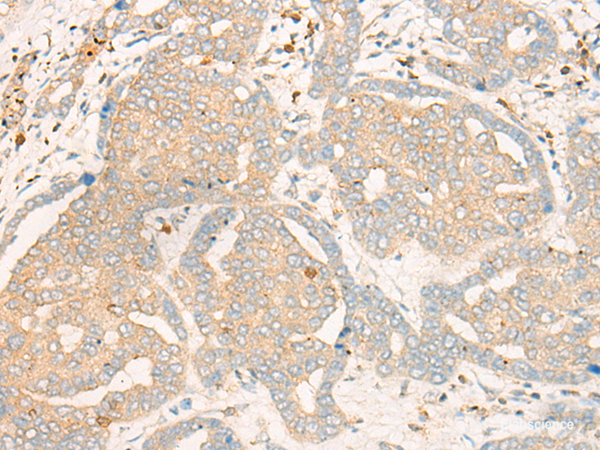
Immunohistochemistry of paraffin-embedded Human liver cancer tissue  using FBXO32 Polyclonal Antibody at dilution of 1:35(×200)

Elabscience
SKU:E-AB-19785
FBXO32 Polyclonal Antibody
FBXO32 Polyclonal Antibody
Couldn't load pickup availability
FBXO32 Polyclonal Antibody
The FBXO32 Polyclonal Antibody is a highly specific and sensitive tool designed for the detection and quantification of FBXO32 protein in various biological samples. This antibody has been meticulously developed and rigorously validated to ensure optimal performance and reliability.
FBXO32, also known as atrogin-1 or muscle atrophy F-box protein, is a key regulator of muscle protein degradation and plays a crucial role in the maintenance of muscle mass. Dysregulation of FBXO32 has been implicated in various pathological conditions, including muscle wasting disorders and neurodegenerative diseases.
The FBXO32 Polyclonal Antibody exhibits exceptional affinity and selectivity towards FBXO32, enabling accurate and precise measurement of its expression levels. This antibody has been extensively tested in a variety of experimental settings, including Western blotting, immunohistochemistry, and immunofluorescence, and has consistently demonstrated outstanding performance.
With its superior sensitivity and specificity, the FBXO32 Polyclonal Antibody offers researchers a valuable tool for investigating the role of FBXO32 in physiological and pathological processes. Its reliable and reproducible results make it an indispensable asset in studies related to muscle biology, protein degradation, and disease mechanisms.
The FBXO32 Polyclonal Antibody is supplied in a convenient and user-friendly format, ensuring ease of use and compatibility with various laboratory protocols. It is manufactured under stringent quality control measures to guarantee batch-to-batch consistency and optimal performance.
Choose the FBXO32 Polyclonal Antibody for your research needs and unlock new insights into the intricate mechanisms governing muscle homeostasis and disease progression.
Share